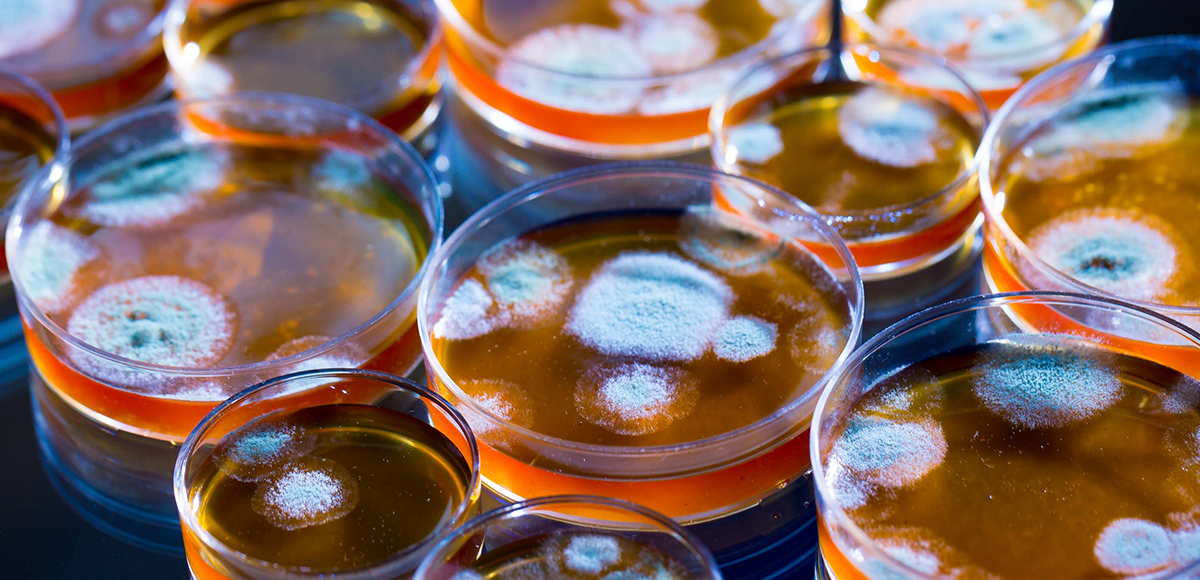

迫られる、新しい医療モデルへのパラダイムシフト
2024.11.15
アメリカの次期大統領がドナルド・トランプ氏に決まりました。
民主党の富裕層だけを優遇するような経済政策などは、一般のアメリカ国民からは大バッシングを受け、蓋を開けてみればトランプ氏の圧勝でした。
日本の衆院選も同じような状況でしたね。
さて今回の大統領選の結果を受けて、ロバート・F・ケネディ Jr.(暗殺された第35代アメリカ大統領ジョン・F・ケネディ氏の甥)氏が、トランプ次期政権で「公衆衛生部門」を統括する厚生長官に就くと発表されました。
そうなると現行の医療モデルは、大きく変わる可能性があります。
現に大手ワクチンメーカーの株価は14日の取引で急落していましたが、トランプ氏がケネディ氏起用の人事を正式発表した後、株価はさらに下落しました。
アメリカのvigilantnewsは、11月7日、製薬業界のトップ5社が緊急会議を招集。
今後の対応・方針を話し合うパニック状態に、と報じていますし、ワクチンの審査機関でもあるFDA(アメリカ食品医薬品局)の職員が大量離職しており、今後さらに増える見込みだとの報道もあります。
ロバート・ケネディ Jr.氏は、トランプ氏と同様に製薬業界や金融、メディアなどの既得権益勢力とは対立する立場で、近年のワクチンの安全性と有効性をめぐる議論に疑問を投げかけている一人でもあります——全米の多くの注目を集めています。
実際、新型コロナ・ワクチンの不正を暴いた彼の著書、『人類を裏切った男 アンソニー・ファウチ / 巨大製薬会社の共謀と医療の終焉』(全3巻)は、全米で100万部を超えるベストセラーとなっています。
トランプ氏やケネディ氏と対立する大手メディアは、これを陰謀論だとしきりに喧伝していますが、すでに多くのエビデンス(論文などの文献)が公表されており、国際情勢をよく知る知識人の間では、大手メディアの報道姿勢に大きな批判が集まっています。
アメリカに従属する日本のテレビなどのマスメディアも同じような論調で、まったく的外れです。
時事ニュースは、テレビや新聞ではなくて、プロのジャーナリストが取材し記事を書く有料のニュースサイトで把握することが大切です。

政権移行チームのキーパーソンであるハワード・ラトニック氏(元キャンター・フィッツジェラルドのCEO)は、以前のメディア出演で、「ロバート・ケネディ Jr.氏がHHS(アメリカ合衆国保健福祉省)の責任者に任命されるのではないか」との質問に対して否定をしました。
しかし、トランプ氏はその翌日「HHSは小さい。ロバート・ケネディ Jr.はすべてを担当する」と述べています。
つまり、疾病対策センター(CDC)、国立衛生研究所(NIH)、食品医薬品局(FDA)など、このようなHHS全体を監督するホワイトハウスの特別職を与えると言ったようなものです。
ちなみに、前述の“人類を裏切った男・アンソニー・ファウチ氏”は米国疾病センター(CDC)の元所長です。
CIA、ホワイトハウス、国防総省の顧問を務めた経験のあるジム・リカーズ氏は、「ロバート・ケネディ Jr.が、MAGA(Make America Great Again/米国を再び偉大な国にしよう)を、MAHA(Make America Healthy Again/米国を再び健全な国にしよう)に変えようとしている」と言います。
実際にトランプ氏は声明で、
〝ケネディ氏がアメリカを再び偉大で健康な国にする〞
と称賛しています。
またトランプ氏はX(旧ツイッター)で、
全ての米国民の安全と健康を守ることは、どの政権にとっても最重要の役割だ。
厚生省が果たすであろう大きな役割は、人々の安全確保に寄与する。
今後は誰もが有害な化学物質や汚染物質、殺虫剤、医薬品、食品添加物から守られるだろう。
こうした物質によってこの国の健康危機は圧倒的な水準に達してしまっている。
としています。
アメリカの医療に大きな変革がもたらされるとすれば、当然ながらアメリカに従属する日本にも大きな影響があります。
そのような憶測から今回の投稿は「迫られる、新しい医療モデルへのパラダイムシフト」と題しておおくりします。
製薬業界の近代史と、医療の新たな方向性を示唆した内容です。

目次
原因療法から対症療法への変遷
原因療法(Root Cause Medicine)とは、疾患の原因を取り除き、根治を目指す治療法で、対症療法(Symptomatic Therapy)の対義語として用いられています。
医学や医療は、ある種の「問題解決法(ソリューション)」ですから、結果(目標と現状のギャップ=問題=症状)をもたらしている「原因」を特定し、課題を設定して対処しなければなりません。
自然界に原因のない結果は存在しませんから、当然のことです。
したがって一般的に対症療法よりも原因療法が望ましいとされますが、原因が不明な症状に対しては行う(問題を解決する)ことができません。

さて、病気は一見、実体のある固定したもののように見えます。
しかし、そのような姿の病気は実在せず、わたしたちが思い描く病気は虚像にすぎません。
心身の「慢性的な不調」を病気と捉えるのは、妄想にほかならないのです。
その妄想は、ゲノミクス(ゲノムと遺伝子の研究分野)という発展し続ける科学によってすでに打ち砕かれています。
20世紀最後の10年と21世紀初頭の十数年に相次いだゲノミクス上の画期的な発見によって、明らかになったことがあります。
それは、心疾患といっても人によって異なり、2型糖尿病を患う人にひとりとして同じ人はおらず、同じ関節リウマチあるいはアルツハイマーと診断された人たちもまったく同一というわけではないという事実です。
こうしたものは病気というより、個人の「生理機能の不具合」なのです。
その原因はさまざまであり、人が一人ひとり違うように、必要な対処法も異なります。
したがって、共通の徴候や症状をひとくくりにして何らかの「病気」と呼べば、適切な薬を見つけるのに便利かもしれませんが、そのようなやり方では、実際に不調をもたらしている原因に対処することはできません。
原因療法の代表的なものが、急性感染症に対して、病原菌を攻撃する抗生物質を用いた化学療法です。
現代の標準医学・医療はこの原因療法の代表である化学療法に端を発していますが、何故今日行われている医療は病気がもたらした影響、つまり症状を抑えるだけの対症療法なのでしょうか?
時を遡ってみましょう…。

Joseph Lister, 1st Baron Lister
製薬産業を産んだ細菌学革命
細菌論は、医療の世界におけるパラダイムシフトと呼んでもいいような事態を引き起こしました。
細菌学による革命です。
医学教育、手術技法、衛生管理や公衆衛生——何もかもが変わり、製薬産業というまったく新しい産業が生まれました。
19世紀が終わる前に、ジョゼフ・リスター(Joseph Lister)、ロベルト・コッホ(Heinrich Hermann Robert Koch)、ルイ・パスツール(Louis Pasteur)といった科学者らが病気の捉え方に革命を起こし、医療を一変させたのです。
これらの科学者が明らかにした細菌論によって、感染症の原因は蒸気ではなく、極微小サイズの生物なのだという考え方が受け入れられるようになりました。
病気の原因になっている微小生物を特定しさえすれば、それに抵抗できるように、体に免疫をつければいいというわけです。
そして今日では、抗原蛋白質の遺伝子に加えて、RNAを複製するためのRNAレプリカーゼの遺伝子をコードしたmRNAワクチン(自己増殖型mRNAワクチンとも呼ばれる)まで登場しています。
製薬業界は免疫をつけるためのワクチンを着実に供給し、20世紀になってからは、ワクチンが効かない感染症を治療できる抗生物質を次々と世に送り出しました。

Shibasaburo Kitazato
北里柴三郎の免疫血清療法の確立と1909年にパウル・エーリッヒ(Paul Ehrlich)が秦佐八郎とともに梅毒に効くサルバルサンを発見したのをきっかけに提唱した化学療法は、その後の医学を大きく変えた衝撃的なものでした。
化学療法の歴史は、前述のサルバルサン、1928年のペニシリンに次いで1935年にドーマク(Gerhard Domagk)によって発見されたスルフォンアミド・プロントジルと続きます。
このプロントジルは、今日でもサルファ剤として使われ続けています。
ペニシリンはアレキサンダー・フレミング(Sir Alexander Fleming, FRS, FRSE, FRCS)博士によって発見されましたが、これは非常に不安定な物質であったため、化学療法剤として実用には至っていませんでした。
しかし、前述のプロントジルの発見も刺激となって再び注目され、ついに、1940年、フローリー(H.W. Florey)、アブラハム(E.P. Abraham)、チェイン(E. Chain)がペニシリンの抽出に成功し、動物、次いで人でその優れた治療効果を証明しました。
「ペニシリンの再発見」は、第二次世界大戦の最中、多くの兵士や市民の命を救いました。
そしてこのペニシリンの成功は、科学者を新たな化学療法剤の探索へと駆り立て行きます。
そして1942年、ワックスマン(S.A. Waksman)が結核に有効なストレプトマイシンを発見、初めて「抗生物質(antibiotics)」という呼び名を提唱し、その後の多くの抗生物質発見の先駆けとなったのです。
Penicillin fungi in petri dishes
まさに目を見張るようなサクセスストーリーでした。
アメリカだけでも、1910年には47歳だった平均余命が、2021年の時点で76.1歳にまで延びています。
細菌論と、それがもたらしたパラダイムシフトのおかげです。
19世紀のご先祖様やそれ以前のあらゆる世代の人々と違って、いまやわたしたちはかつてあれほどの災厄をもたらした致命的な感染症をむやみに恐れなくてもよくなっています。
麻疹(はしか)のように、完全には消滅していない感染症はあるものの、そうしたものにも治療薬があります。
しかし残念ながら、心配の種がまったくなくなったわけではありません。
ワクチン接種と抗生物質治療によって感染症は以前より少なくなり、脅威も小さくなったとはいえ、別の一群の病気が幅をきかせ始めています。
新型コロナではありませんよ。
それより遥かに大きな脅威となっている疫病です。
それが慢性疾患(生活習慣病)です。
ここで言う慢性疾患とは、わたしたちの健康を損ね、決して消えないあらゆる異常や病気、心身の不調を指します。
それらが自然に治ることはなく、ずっと居座って、何度もぶり返します。
悪影響をなんとか管理して、たまには一息つけることもあるものの、感染症をやっつけたようにきれいさっぱり打ち負かすことはできません。
何かにつけわたしたちを弱らせて能力をそぎ、寿命を縮めます。
被害の規模からすれば、わずかな脅威しかない新型コロナに大騒ぎして、すでに日常的な大きな脅威である慢性病には無関心を装う現代の医学界はどこか異常です。

Depression Symptoms (serious medical illness that negatively affects how you feel, the way you think and how you act) mind map text concept background
薬剤による対症療法のはじまり
化学療法の成功に気を良くした製薬業界は急性感染症以外にも目を向け始め、慢性疾患と診断された人々を苦しめているような種類の病気にも手を広げるようになりました。
そしてこれらの動きの原動力となったのが、石油利権(スタンダード石油)で大儲けをしたロックフェラーの潤沢な資金です。
彼らの資金は、医科大学の買収や設立、現行の医療システムの構築などに投じられ、社会的・政治的に大変革をもたらしました。
彼らは、慢性疾患のような病気については、感染症を引き起こしている特定の病原体のようなものは見つからないだろうとわかっていたため、その慢性疾患の「主症状に関連のある生理プロセス」を突きとめることを目指しました。
症状が痛みであれ、炎症であれ、病気に伴う代謝活性の具体的な逸脱であれ、関連する生理プロセスを突きとめさえすれば、その影響を緩和できる薬、代謝の複雑なネットワークにおける逸脱を阻止または改変できるような薬を開発できるだろうと考えたわけです。
これが薬剤による対症療法のはじまりです。
そうした薬を創り出すためにこれまでとは異なる開発方法が考案され、それが製薬産業の姿を根本から変えることとなり、現在では巨大な産業となっています——アメリカでは最大利権です。
開発の第一段階はいわゆる高速大量スクリーニング(Screening)で、 —— 大量のものを検査して、条件に合うものを選び出す行為 —— 実験室で合成された何万という化学物質について、標的とする代謝活性にどのような影響を及ぼすかを厳密に評価します。
代謝過程の特定のステップへの干渉に必要な量が少なければ少ないほど、その化学物質は活性が高く、薬としての効力が大きいと考えられます。
次に、効果が高いとわかった化合物の安全性を、一定の多様なモデルについて調べます。高い活性をもち、安全基準も満たした物質は、今度は人間でテストされ、もしテストに通れば薬として市場に出回ることになります。
つまり、医師が処方できるわけですが、その薬はあくまでも、ある代謝過程における特定の逸脱によって引き起こされた急性疾患を治す「短期療法」のために開発されたものです。

Medicine Development Laboratory: Asian Female Scientist Using Microscope, Analyzes Petri Dish Sample. Big Pharmaceutical Lab with Specialists Conducting Biotechnology Research, Developing New Drugs.
ここに慢性疾患が関わってくると、厄介なことになります。
なぜなら、いま増えつつある慢性疾患という病気(生理機能の不具合)は、複雑な代謝ネットワークにおける単一のステップの変質に原因があるわけではないからです。
私たちが慢性と呼ぶ病気や状態はむしろ、さまざまな原因によってもたらされたもので、それぞれが独自の症状あるいは症状群を示します。
そして開発された薬剤は主症状——病気の根本原因ではなく病気による影響——のみを治療するものであるため、薬剤でどれほど頻繁に叩こうと、どれほど多種類の薬剤で叩こうと、慢性疾患を根本から克服することはできません。
いつまでも居座ったり、ぶり返したりします。
それどころか、しだいに悪化します。
治療しても健康を取り戻すことはできず、むしろ障害がひどくなり、生活の質(QOL)が低下するのです。
急性疾患用に開発された薬剤の弊害
何が間題なのでしょうか?
あなたは医師に、〝疲労感があり、体中にうずくような痛みがある〞と訴えます。
もっと具体的にと促されると、〝よく眠れない、集中力が続かない、気力が湧かない、ただもう疲れ果てた感じがする〞などと言います。
製薬会社の戦略にのっとった教育を受けた医師は、せいぜい途方にくれるしかありません。
この気の毒な患者をどうしたら助けられるのだろうか?
なにしろ、その製薬会社の戦略というのが、ひとつの病気はひとつの原因で説明でき、ひとつの原因はひとつの薬で治療できるので、その原因を探せばいいというものなのです。
熱意あふれる医師ほど、多くの症状を和らげてやりたい一心で複数の薬を処方します。
ほかにいったい何ができるでしょうか?
患者が訴えているような多くの症状をもたらす原因のための薬はありません。
なぜなら、その原因は複雑で多くの面をもち、単一の薬で治せるようなものではないからです。
しかし、成長著しい製薬産業のおかげで、個々の症状向けの薬はふんだんにあります。
我が国では、18,000種以上の医薬品が流通しているといいます。
というわけで、たとえば同じ2型糖尿病でも、患者の訴える症状に応じてさまざまな薬が処方されることになります。
疲労感があるならこの薬、食欲を抑えたいなら別の薬、頭痛にはまた別の、そして目のかすみにはさらに別の薬という具合です。
関節炎のある人なら、不快感を和らげるための鎮痛剤と併せて、さまざまな抗炎症剤を服用することになるでしょう。
特定の感染症の原因に対処する抗生物質と違って、こうした慢性疾患を患う人に処方される薬は病気の影響を治療しているのであって、その多種多様な原因を治療しているわけではありません。
こうした治療は「多剤投与」と呼ばれ、ひとつの病気がもたらすさまざまな症状に対処するために、いくつもの異なる薬を同時に投与します。
もし病気が2つ以上、たとえば糖尿病に加えて関節炎もあるという場合は、当然、多剤投与もさらにエスカレー卜します。
はっきりわかる病状3つに対して6種類もの薬をのんでいる人もいるでしょう。
治療熱心な医師たちが、患者の関節炎、心血管系の虚弱、それに骨粗鬆症の可能性がもたらす影響を薬で抑えて、なんとか日常生活に支障が出ない程度に収めようとしているわけです。
しかしそれはごまかしであって、おおもとの原因にはまったく取り組んでいないのです。

Antibiotic-associated diarrhea (AAD) concept with woman have an upset stomach, side effects from overusing antibiotics medicine often or long-term
その結果、何が起こるでしょうか?
ひとつには、病気がしだいに進行します。
すると症状がいっそう重くなり、緩和にはさらに多くの薬が必要になります。
そして、患者は実上、死ぬまで薬をのみ続けることになります。
しかしそれらの薬は本来、症状があっても元気に生きていけるように、はっきりと「期間限定の服用」を目的につくられ、承認されたものなのです。
元気に生きるどころか、実際には患者は薬をのみ続けることで命を危険にさらしているというのが実態です。
というのも、薬の副作用をますます受けやすくなるからです。
「副作用」と聞くと、ささいな不都合のような印象を受けるかもしれませんが、薬剤に主作用も副作用も、ましてや副反応などというものはありません。
それらすべてを合わせて「作用」なのです。
「副」というのは患者を心理的に誤魔化すためのものです。
実際には、これが米国での主要な死因になっています。
ウォール ストリート ジャーナル紙は、現在、米国の子供や10代の若者の4分の1以上が処方薬を慢性的に服用しており、そのうちの約7%が2種類以上の薬を服用していると報じています。
インフルエンザワクチンや抗うつ剤は妊婦に処方されますが、胎児に悪影響を与えることが知られており、その結果、子供が将来的に慢性的な症状に悩まされることになります。
また、CDCによると、全アメリカ人の半数が処方薬を定期的に服用しており、約3分の1が毎日2種類以上の医薬品を使用しており、全アメリカ人の10パーセント以上が5種類以上の薬を同時に服用していることが多いそうです。
これらの統計を考慮すると、米国医師会雑誌 (JAMA) が、致死的な薬物有害反応 (FADR) が現在米国における死亡原因の第 1 位であると報告していることは驚くに当たりません。
前述の通り、医薬品の安全性試験は限られた期間の使用を念頭に行われるもので、生涯にわたって使用することは想定していません。
短期間の試験では安全に見えるものが、長期間使用しているうちにまったく違う効果を見せ始めることがあります。
とりわけ、遺伝子構成も生活習慣も病気の原因も、まったく異なる大勢の人々が使用した場合に、そうしたことが起こりやすい。
どんな薬であれ、承認過程における試験よりも大幅に長い年数、大勢の人が使用した埸合は、「意図しない作用」が現れてもおかしくないのです。
さらに、多剤投与されたそれぞれの化学物質が、体内でどのような化学反応を引き起こし、どのような物質が生成されるのかといった研究はほとんどないというのが実態です。

慢性疾患とはどのような病気か?
では具体的に、慢性病にはどのような病気があるのでしょうか?
ありとあらゆる苦痛や脅威のもととなるそうしたなじみ深い病気には、次のようなものがあります。
・2型糖尿病、痛風、高血圧、認知症のような心血管疾患
・関節炎のような自己免疫性炎症性疾患
・うつ病、注意欠陥障害、自閉症のような神経障害
・逆流性食道炎、十二指腸潰瘍、炎症性腸疾患などの消化器疾患
・骨租鬆症のような骨量の減少
・閉塞性肺疾患や喘息
・慢性疲労症候群や線維筋痛症による筋肉痛や筋力低下
・腎臓や肝臓の病気
・黄斑変性や網膜症のような視覚障害
・ガン
これらを「慢性疾患」としてひとくくりにできるのは、4つの際立った特徴があるからです。
第一に、不調がひとりでに治ることはありません。
専門用語では「自己限定性」でないと言います。
たとえば風邪は自己限定性で、一定の経過をたどって消えていきます。
慢性的な不調はそうはいきません。
第二に、不調が時とともに悪化するということです。
こうした不調をわたしたちは——少なくともこれまでは——和らげることはできても消し去ることはできませんでした。
そのため、二度と健康を取り戻せず、ぶり返す症状への対処が永遠に続くことになります。
第三に、これと指摘できるような単一の原因がなく、いくつかの要因または原因物質が関わっていることです。
第四に、症状が複雑なパターンを示す傾向があること。
患者の訴える症状は千差万別で、病気の徴候もさまざまです。
ありふれていながら複雑で、原因もひとつではなく、特定しにくい多くの要因が関わっている——そんな慢性疾患と共に、私たちは生きていかなければならなくなっています。
ますます多くの人が慢性疾患を抱え、生活に大きな負担を強いられています。
実際、思い切った変革を起こさないかぎり、私たちは虚弱で病気がちの老年へとまっしぐらというのが実態です。
病院通いに多大な費用と時間を費やし、薬漬けの毎日を送るようになるでしょう——というか、もう既にそうなっています。
日本人の生涯医療費は約2800万円と言われ、その多くを国が負担しているわけですが、個人の窓口負担も相当な金額です。

People sitting in the waiting room at the hospital, they have different diseases and injuries, healthcare and emergency concept
この慢性疾患という重荷の増加が、世界全体の医療システムにただちに難しい課題を突きつけることは、考えなくてもわかります。
しかし困ったことに、私たちの医療システムはそうした挑戦に準備ができているとは言えないのです。
確かに今はすばらしく高度な医療インフラがあり、感染症や救急治療に威力を発揮しています。
具合が悪くなったり怪我をしたりしたときには、かかりつけの医師に診てもらうか、病院やクリニックに行くことができます。
傷は縫い合わされ、病気には診断が下され、手には処方箋をもたされて、一件落着です。
日本は人口あたりの病床数や高額医療機器の保有数でもダントツの世界一です。
こうしたインフラに関するすべて——医師やその他の医療専門家の教育訓練、治療の方法や手段、病院やクリニックの組織、それに言うまでもなく保険や診療費の払い戻し——はもっぱら、単一の原因による伝染病の治療や、急な怪我または心臓発作や脳卒中のような突発的なできごとの修復を対象としています。
残念ながら、「この病気にはこの治療」というこうしたシステムは、いまわたしたちを現実におびやかしている慢性疾患への対処にはまったく向いていません。
治療を任されている医師やその他の医療専門家の臨床教育についても、事情は同じです。
米国および世界中のメディカルスクールは、医師を危機的状況の治療の専門家になるべく訓練することに関してはすばらしい仕事をしています。
しかし、慢性疾患をどう管理するかは、ほとんど教えていません。
この落差は数字にも表れています。
慢性疾患の管理に医療関連支出の80パーセント近くが充てられているのに、医師の訓練に占める時間はほぼゼロなのです。

ご存知のように、わたしたちの体はさまざまなシステムからなるネットワークです。
循環器系、消化器系、神経系、内分泌系、免疫系、生殖器系、呼吸器系、リストはまだまだ続きますが、どのシステムも、協力し合って生命維持機能をこなす多くの器官からなっています。
循環器系では心臓と血管が協力して血液を全身に送り出します。
神経系では脳、脊髄、神経が情報を受け取って処理し、体にさまざまな指令を出します。
呼吸器系の肺、気管、咽頭が協力して各システムに酸素を行きわたらせ、体を機能させ続けます。
それぞれのシステムにとって、円滑かつ最高の作動状態を維持するのは容易なことではありません。
そのうえ、システム同士が複雑なネットワークを介して互いに作用し合います。
これが、ダイナミックに動き続ける生命活動をさらに複雑にします。
したがって、体の仕組みがどうなっているのか考えを巡らすときには——体調がすぐれないときにはそうするのが自然ですが——こうしたシステムを構成する器官がお互いに、また他のあらゆるシステムと、どのような関係にあるのかを考えなければならないのです。
医療費をつぎこめばつぎこむほど、成果は遠のく
医学は最も若い科学です。
医学の理論はなく、慢性疾患という未知の海を航海する助けになるような羅針盤はありません。
そしていまの医療モデル、つまり医療従事者の教育法や彼らが用いる治療戦略は、そうしたシステム重視の考え方には基づいていません。
もともと細菌論から導かれたため、還元主義※的思考法に基づいています。
つまり病原菌を見つけ、専用に開発された薬でやっつければ一件落着という考え方なのです。
急性疾患の治療にはめざましい成果を発揮したモデルですが、生体機能をつかさどるシステムやそれらをつなぐネットワークのバランスの回復や維持となると、明らかに手も足も出ないのです。
※還元主義:複雑で抽象的な事象や概念を、単一のレベルのより基本的な要素から説明しようとする立場。とくに科学哲学では、観察不可能な理論的概念や法則を直接的に観察可能な経験命題の集合で置き換えようとする実証主義的傾向をさす。

かつて、急性感染症は治療法のない恐ろしい病気でした。
抗生物質が登場する前は、単純な産褥熱で女性が亡くなり、たちの悪い肺病にかかれば命の保証はありませんでした。
連鎖球菌による咽頭炎が心臓麻痺につながり、傷の化膿が原因で手足が切断されました。
そうしたことが当たり前だった時代があったとは、いまでは想像することさえ難しいのではないでしょうか。
とはいえ、こんにち私たちが直面している慢性疾患の急増ぶりを見れば、事態は少しも変わっていないことがわかります。
急性感染症から慢性疾患に病気の種類が変わっただけなのです。
そして慢性疾患はますますありふれたものになりつつあり、しかもかつてない速さで増えています。
1985年から 2010年までの四半世紀で、糖尿病、心疾患、慢性閉塞性肺疾患と診断される人の数が劇的に増えました。
脳卒中やうつ病も増えていますし、多くの人が骨粗鬆症による骨量減少、筋力の低下、腎臓や肝臓の病気、加齢黄斑変性や老眼に悩まされるようになっています。
子どもの自閉症や成人の認知症の発生率も驚くほど増加しています。
そして欧米では減少傾向にあるガンは、ここ日本だけが急増傾向を維持しています。

ガンによる死亡率比較(日本・アメリカ・フランス)人口10万人あたり

出典:『令和五年(2023)人口動態統計月報年系(概数)の概況』厚生労働省
慢性疾患は今後20年で世界経済に47兆ドル(約7千167兆9465億円)のコストをもたらし、世界中で感染症の2倍の死者を出す勢いです。
これは一国の経済を破綻に追い込みかねない額です。
そして医療費をつぎこめばつぎこむほど、成果は遠のいています。
アメリカは先進国のなかで治癒率も平均余命も最低です。
心臓病、糖尿病、ガン、自己免疫疾患、消化器疾患、認知症、アレルギー、喘息、関節炎、うつ病、注意欠陥障害、自閉症、パーキンソン病、そして早熟や不妊のようなホルモンの問題——こうした心身のさまざまな不調が、わたしたちを苦しめ、経済的に疲弊させています。
いまやアメリカ人の2人に1人が慢性疾患を患い、医療費の80%がその治療に充てられています。
しかし、次々に現れる新しい薬や治療法にもかかわらず、慢性疾患の発症率は上がり続けています。
このような悲惨な公衆衛生の状況を鑑み、トランプ氏が冒頭の声明を発表するのは、一国のリーダーであれば当然のことです。
発展途上国の人々がアメリカ人の最悪の食習慣や文化を取り入れるにつれ、発症率はアメリカだけでなく世界中で増加傾向にあります——TPPをはじめとしたグローバル経済の悪影響です。
戦後もっともアメリカの悪影響を被った日本は、その先頭を走っています。
医療行政も医療現場も大学の医学部(メディカルスクール)を卒業した優秀な人々が運営し、さらに45兆円以上もの莫大な医療費を使っても病人を減らすことができていません。
それどころか、年々増加している始末です。
財務省が国家財政を云々するのであれば、まず手をつけなければならないのは「国民医療費」です。
怪我や出産など一部を除いて、国民医療費を「予防医療」に振り向けることで、費用は大幅に削減され、国民の意識にも大きな変革がもたらせるでしょう。
しかし残念なことに我が国には、アメリカや巨大な製薬業界に立ち向かい、財務省を解体して、この異常事態を解決しようという政治家は見当たりません。
政府は当てになりませんから、わたしたち国民の一人ひとりが、ヘルスケアリテラシーを高め実践していくしかありません。

求められる新しい医療モデル
このパラドックスの行きつく先は誰の目にも明らかです。
いまのやり方では問題を解決することはできません。
繰り返しますが、現行の治療モデルは急性疾患を治すために考えられたものです。
不調をもたらす単一の原因、つまり微生物を特定し、それに効く単一の手段、つまり抗生物質を開発した結果、急性疾患のほとんどが克服されています。
この治療モデルの成功を受け、あらゆる病気に対して、その特効薬となる薬の探索が試みられるに至りました。
しかし探索は失敗に終わり、別のパラダイムが求められています。
慢性疾患というこの新しい疫病を診断し治療するための、「新しい原因療法モデル」が必要とされているのです。
考え方を180度変えることは容易ではなく、既得権益を護るために新しいやり方を中傷する人々はどこにでもいます。
しかしいまやエビデンス(証拠)は出揃い、現行のやり方が失敗であることは、医療に関心のあるどんな人の目にも明らかです。
いまこそ、多くの人々の無益な苦しみを終わらせる力を秘めた新しい考え方への転換を図るべきです。
ホリスティック医学による健康へのアプローチ
「機能性医学(Functional Medicine)」と「ライフスタイル医学(Lifestyle Medicine)」は、病気や疾患、一般的な健康問題を治療する非常に一般的なホリスティックな 2 つの方法ですが、どちらかのアプローチが優れているというわけではありません。
これらの 2 つのホリスティックな方法は、症状の治療だけでなく、健康問題の根本的な原因の治療に患者中心の焦点を当てているため、急速に変化する米国の医療業界でよく知られています。
機能医学とライフスタイル医学はどちらも、健康に対するホリスティックなアプローチを活用しています。
国立衛生研究所によると、ホリスティック医学は次のように定義されています。
ホリスティック医学は、特定の技術セットではなく、ヘルスケアに対する態度的なアプローチです。健康と病気の心理的、家族的、社会的、倫理的、精神的、および生物学的側面に対処します。
患者は人間です
ライフスタイル医学と機能性医学のホリスティックなアプローチを通じて、患者は人間として扱われ、ケアされます。
そして患者には、自分の健康をコントロールする能力が与えられます。
ライフスタイル医学と機能性医学の両方が、人々に健康上の決定の結果に関する情報と、最高の健康状態に到達するための賢明な選択を行う方法を提供します。
個別化されたヘルスケア
これは、両方の戦略の主な焦点です。
患者は、グループや統計としてではなく、独自の健康状態を持つ個別の個人として見なされます。
個人として扱われると、健康計画はより詳細で戦略的になります。
予防を通じて健康問題に取り組む
ライフスタイル医学は機能医学よりも予防を重視していますが、どちらのアプローチも健康問題の根本的な原因を治療し、慢性疾患の発症を遅らせることに専念しています。
アプローチは異なりますが、機能性医学とライフスタイル医学は、人々が自分の健康を管理できるようにするという同じ目的を持っています。

機能性医学による健康へのアプローチ
機能性医学は、1990年にアメリカのジェフリー・ブランド(Jeffrey Bland)博士によって提唱された「最先端科学と医学を融合した、生活習慣病や慢性病の治療法」です。
翌年には米国で機能性医学会が設立され、その後、多くの学者に支持、研究されてきました。
ビル・クリントン(元アメリカ合衆国大統領)が選んだ次世代医療としても知られています。
■機能性医学の定義(機能性医学の教科書より)
Functional Medicine is personalized medicine for complex chronic disease that focuses on primary prevention and treatments designed to address underlying causes instead of simply symptom suppression.
機能性医学とは、発症メカニズムが複雑である慢性疾患に対して、対症療法に終始するのではなく、発症原因に着目しながら、その予防と根本治療を目指す、個体差を考慮した医学である。
これは基本的に、機能性医学の専門家が症状や健康問題の原因を特定するアプローチを使用することを意味し、健康に対する実践的で調査的なアプローチです。
機能性医学は、ライフスタイル医学よりも根本原因と診断に重点を置いています。
症状の根本原因を突き止めるには、診断と検査によって次のステップが導かれます。
診断と個別ケア
機能医学の患者中心のアプローチはよく知られています。
医療現場では、健康問題の根本原因を特定するために高度な診断検査が使用されています。
ホルモン、マイクロバイオーム、栄養、遺伝学の評価は、機能医学の検査の一部であることがよくあります。
機能性医学を専門とする家庭医療では、特定の不均衡を示す可能性のあるこれらの検査結果に基づいて、個別の治療プログラムを作成します。
根本原因アプローチ
病気の根本的な原因を治療することは、機能医学の基本的な要素です。
これには、患者のライフスタイル、病歴、周囲の状況を詳細に調査して、健康問題の原因を特定する必要があります。
治療の目標は、不均衡を調整し、最高のパフォーマンスをもたらすことです。
栄養中心
機能性医学の重要な要素は栄養です。
専門家は、自然食品、抗炎症食の必要性を強調し、食事過敏症を見つけるために、除去食などの特別な食事を頻繁に使用します。
これは、過敏性腸症候群(IBS)、代謝の問題、または甲状腺機能低下症の根本原因を特定しようとするときに特によく見られます。

Functional medicine as disease treatment with looks for root cause outline diagram. Tree with cancer, heart disease and diabetes health problem identification and focused help vector illustration.
ジェフリー・ブランド(Jeffrey Bland)博士は、著作『The Disease Delusion-Conquering the Cause of Chronic Illness for a Healthier, Longer, and Happier Life(機能性医学入門-慢性疾患の予防と治療)』において以下のように述べています。
生活全般に影を落としている慢性疾患の根底にある機能異常のパターンを調べ、そうした不調を防いだり元に戻したりできる治療モデルを提示する。
その治療モデルはどのようにして効果を発揮するのだろうか?
本書を読めばいっそうよく理解できるはずだが、ここでは、遺伝子が周囲のできごとや私たちの行動にどう刺激され、どう応答するかに基づいているとだけ言っておこう。
基本的に、後者すなわち環境や行動を変えることができれば、前者を変えることができる。
つまり私たちは遣伝子がどう刺激されるか、どう反応するかを調整できる。
そして、遺伝子が生命活動を制御あるいは指揮しているのだから、結果的に健康状態のパターンも調整できるのだ。
これはゲノム革命から生まれた新しい科学だ。
ゲノム革命によって、遺伝子と個性との関係についての新しい理解がひらけた。
私たちはどのようにして、遺伝子型から表現型になるのか、もって生まれた潜在的な可能性のかたまりから、どのようにして、一定の個性を備えた唯一無二の存在となるのか。
この新しい科学は、そうしたことは受胎時に遺伝子に刻まれた青写真であらかじめ決まっているのではないと教えてくれる。
一生を通じて、遺伝子型が環境とどのように作用し合い、私たちの中核的な生理プロセスからどのような応答を引き出すかによって、決まるのだ。
遺伝子と個性の発現との関わりに関する理解がこれほど根本的に変わったからには、医療にも当然、新しいモデルが求められる。
そうした相互作用を重視したモデル、中核的な生理プロセスがどう機能しているのか、どうすればうまく機能するのかを中心に据えたモデルが必要になる。
それを提供するのが機能性医学だ。
通常の医療モデルでは、病気の症状に注目し、何らかの診断を下すことを最重要視する。
統合医療や代替医療のモデルでは、昔から用いられてきた多種多様な治療法を提供し、好きなものを選ばせる。
これに対して機能性医学では、最新のバイオメディカル分野の成果を武器に、一人ひとりの健康問題の根底にある原因を探ることに力を注ぐ。
機能性医学が、そうしたバイオメディカル分野の発見やテクノロジーを私たちの時代持有の健康問題、つまり慢性疾患に適用するのは当然だ。
なぜなら機能性医学では、問題の根本原因を、個人の遺伝的な特性と生活習慣や環境や日常の食事との相互作用に求めるからだ。
根本原因を突きとめたのち、患者と医師が、その患者個人に合った健康管理プログラムをつくる。
必要に応じて、患者の環境や食事、生活習慣の変更と薬の使用を組み合わせるが、単に患者の苦しみを和らげるだけでなく、遺伝的な潜在能力を最大限に引き出して活力と長寿を実現できるよう心掛ける。

ライフスタイル医学による健康へのアプローチ
アメリカライフスタイル医学会によると、ライフスタイル医学は次のように定義されています。
ライフスタイル医学は、心血管疾患、2 型糖尿病、肥満などの慢性疾患を治療するための主な手段として治療的ライフスタイル介入を使用する医療専門分野です。ライフスタイル医学認定臨床医は、エビデンスに基づいた、人全体を対象とした処方的なライフスタイル変更を適用して、これらの疾患を治療し、集中的に使用すれば多くの場合回復させるように訓練されています。ライフスタイル医学の 6 つの柱、つまり自然食品、植物中心の食事パターン、身体活動、回復のための睡眠、ストレス管理、危険物質の回避、ポジティブな社会的つながりを適用することで、これらの疾患を効果的に予防することもできます。
これらはすべて何を意味するのでしょうか。ライフスタイル医学は、6 つの柱の方法で日常生活の過ごし方を変えることで、人の健康に専門的なアプローチをすることです。
これらの 6 つの柱には、①食事 (特に自然食品と植物ベースの食事)、②身体活動、睡眠習慣、③個人的なストレス管理、④社会活動、⑤薬物や⑥アルコールなどの物質の回避が含まれます。
ライフスタイル医学は、機能医学よりもライフスタイルに重点を置いています。
健康的な食事と適切な運動が健康を改善することは間違いありません。
しかし、誰もが同じではありません。
すべてのダイエットプランがあなたに適しているわけではありません。
そこで、パーソナライズされたライフスタイル医学プランを専門とするヘルスコーチが役立ちます。
行動介入
ライフスタイル医学の目標は、行動介入を通じて健康を向上させることです。
栄養、運動、ストレス軽減、睡眠パターン、薬物使用の変更は、その一部です。
専門家は患者と密接に協力して、健康を促進するライフスタイル・プログラムを作成します。
予防の重視
予防は両方の戦略の目標ですが、ライフスタイル医学ではさらに重点が置かれています。
より健康的なライフスタイルの選択を採用することで病気を予防することに重点が置かれています。
これには、慢性疾患を発症する可能性を下げるために、体重管理、禁煙、ストレス管理が含まれる場合があります。
多分野にわたるチーム
ライフスタイル医学では、人の生活のさまざまな側面を治療するために、医師、栄養士、理学療法士、精神衛生の専門家などの医療専門家のチームが協力して取り組む必要があります。
さまざまな専門分野を持つ医療行為が、健康的なライフスタイルのために団結して取り組むことで、ライフスタイルを変えることで人の人生を変えることができます。

弊社、三保製薬研究所の創業に深く関わった、西勝造が創始した西医学健康法は、諸科学を総合統一し、世界で初めて体系化された健康医学(ホリスティック医学・原因療法)の先駆けです。
西医学健康法の創始は1922年(大正11)、これを一般に公開したのが1927年(昭和2)で、ほぼ100年の年月が過ぎました。
筆者は、西医学健康法を進化させた先にあるのが、機能性医学やライフスタイル医学であろうと考えています。
それぞれに違いはありますが、根幹の考え方は同じです。
いずれにせよ、まず優先すべきは「予防」です。
生理機能に不具合(病気)を引き起こさぬよう、食生活をはじめとした「ライフスタイル」を見直すことが重要です。
しかし、もし体調に何らかの不調を感じたとしたら、それには必ず原因があり、そのほとんどはあなたのライフスタイルの中にあります。
健康な状態に戻すためには、〝この不調の原因は何だろう?〞と考えてみてください。
毎日の排泄は食べた回数以上ありますか?
食べ過ぎていませんか?
偏った食事をしていませんか?
不健康なフェイクフードを食べていませんか?
多様な栄養を摂取できていますか?
運動をしていますか?
よく眠れていますか?
人間関係にストレスはありませんか?
わたしの「生き方」のどこに問題があるのだろう?と謙虚に振り返ることです。
一方、〝この症状を抑えるにはどうしたらいいのだろうか?〞と考えた場合、生理機能不全を克服するのは困難となるでしょう。
今日、地球を苦しめている慢性疾患を見てみましょう。
がん、心臓病、アルツハイマー病、自己免疫「炎症性疾患」、消化器疾患、COPD、肥満、糖尿病、無数のウイルス性および細菌性感染症、変形性関節症、筋骨格障害などです。
マグネシウム欠乏症との関連は議論の余地がありません。
現代医学は、薬が唯一の解決策であるという近視眼的な見方を支持し、自らの科学的根拠を無視してきました。 (時々そうなることもありますが!)
これらの慢性疾患は、地球上の大多数の人々の生活の質を奪っているだけでなく、医療資源を劇的に奪っています。
1960 年、米国の医療費の平均年間額は146ドルでした。
2017年までに、メディケアおよびメディケイド サービス センターのレポート「1960~2017年のGDPシェアを含む国民医療費の概要」によると、この額はなんと10,739ドルにまで上昇しました。
私の結論はシンプルです。
私たちは医療制度が原因ではなく、症状に主に焦点を当てることを許してきました。
この治療パラダイムは生物学と薬理学を無視しています。
その結果、持続不可能な医療制度が生まれたのです。
アルバート・アインシュタインの言葉を引用させてください。
〝どんな賢い愚か者でも物事を大きく複雑にすることはできる…逆の方向に進むには天才的な才能と多くの勇気が必要だ。〞
ロン・ハニングヘイク医学博士(Ron Hunninghake, MD., Ph.D.)
Chief Medical Officer, Riordan Clinic, Wichita, Kansas, USARiordan Clinic(リオーダン・クリニック)は、世界で最も有名な静脈内ビタミンC(IVC)注入及びビタミンC関連の臨床及び基礎科学研究を行っている医療機関です。同クリニックでは、ビタミンCやマグネシウムなどの栄養素を含む弾性膀胱形式の投与が利用されており、個人が24時間にわたって制御された遅延静脈内注入を外来で受けられるようになっています。

References
“The Disease Delusion-Conquering the Causes of Chronic Illness for a Healthier, Longer, and Happier Life” by Jeffrey S. Bland
北里一郎『 ペニシリンの半世紀』日本化学療法学会雑誌
梶本哲也『ペニシリンの発見から製品化までの道のり』科学と教育67巻11号 2019年
『令和五年(2023)人口動態統計月報年系(概数)の概況』厚生労働省
“Magnesium: Reversing Disease” by Thomas E. Levy